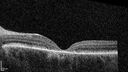
stargardts_2020_105079_07.jpg

|
|

Advanced age-related macular degeneration97 views87 year old female. Severe macular bleed 15 years ago OD. Now with disciform scar. Left eye has progressing geographic atrophy.
VA OD: HM, OS: 5/200. IOP normal OU
|
|

Posterior Pigment Dispersion Syndrome97 views81 year old man with cataract surgery 30 years ago and normal vision who had bilateral vitrectomy for dense floaters and has pigment on his IOL surface and all over the retina (but not on the cornea) VA 20/25 OU
|
|

Fresh BRAO in patient with wet AMD97 views91 year old female She noticed last night a shadow over the left eye. When she closes her right eye she cannot see the bottom of the vision in the left eye. This is new.
VA OD: sc20/32-1
VA OS: sc20/32-2
|
|

Central Retinal Vein Occlusion with cilioretinal artery occlusion97 views63 year old female who lost vision in the left eye 2 days ago. She was in the emergency room and had a lot of tests done which were all reportedly normal. The right eye is OK.
VA OD: Dcc20/25 NccJ2
VA OS: Dcc20/200-1 PHNI Ncc20/400-1
IOP: TP: OD:11 OS:12
|
|

Central Retinal Vein Occlusion with cilioretinal artery occlusion97 views63 year old female who lost vision in the left eye 2 days ago. She was in the emergency room and had a lot of tests done which were all reportedly normal. The right eye is OK.
VA OD: Dcc20/25 NccJ2
VA OS: Dcc20/200-1 PHNI Ncc20/400-1
IOP: TP: OD:11 OS:12
|
|

Choroidal Melanocystosis97 views65 year old female with normal vision.
|
|
Stargardt - Mother with Stargadts and father with RP97 viewsHer mom is genetically visually impaired with Stargardts. Her father has RP. The mother was genetically tested in Boston about 23 years ago. That was when the gene was first being isolated. (The mother has seven brothers and sisters and four have stargardts and they are legally blind. Also one cousin has it.)
VA OD: 20/160 OS: 20/160
She tested positive for ABCA4
|
|

Syphilitic Chorioretinitis97 views41 year old man with vision loss for five days left eye. VA 20/32, 20/200
|
|

Severe NPDR97 views53 year old man with blurred vision (needs glasses).
Diabetic for 10 years with poor control
VA 20/32 OU
|
|

Pattern Dystrophy - PHPR2 Gene97 views57 year old man- VA 20/25 OD, 20/20 OS - Many family members have retinitis pigmentosa
|
|

Pseudophakic CME chronic97 views74 year old man presented 14 weeks after cataract surgery with severe CME on topical therapy. Multiple attempts to taper drops failed. Also, the patient had a steroid responsive glaucoma. He ended up on BID PF, Ketorolac and Dorz/Timolol
|
|

Pseudophakic CME chronic97 views74 year old man presented 14 weeks after cataract surgery with severe CME on topical therapy. Multiple attempts to taper drops failed. Also, the patient had a steroid responsive glaucoma. He ended up on BID PF, Ketorolac and Dorz/Timolol
|
|

Myopic CNVM Left Eye97 views80 year old female. VA dropped to 20/125 but improved back up to 20/50 with Vabysmo
|
|

Choroidal Metastatic Breast Cancer with Exudative Detachment97 views58 year old female presented with 20/200 vision. Had 10 sessions of radiation and tumor shrank. The exudative detachment took almost a year to resolve. The vision improved to 20/40.
|
|

Wet AMD - Occult CNVM and Geographic atrophy97 views77 year old female with mild vision loss - 20/32 - responded to Avastin
|
|

Wet AMD - Occult CNVM and Geographic atrophy97 views77 year old female with mild vision loss - 20/32 - responded to Avastin
|
|

Wet AMD - Occult CNVM and Geographic atrophy97 views77 year old female with mild vision loss - 20/32 - responded to Avastin
|
|

Prethreshold PDR right eye - mild NVD97 views
|
|

Prethreshold PDR right eye - mild NVD97 views
|
|

Bietti's Crystalline Dystrophy - CYP4V2 homozygous96 views58-year-old-female (from Thailand)
Patient had evaluation for LASIK and there was concern that the BCVA was not normal.
PMHx Benign, Meds: none
VA 20/25 OU
|
|

Paracentral acute middle maculopathy - isolated96 views83 year old man New spot in the vision yesterday left eye.
Medical Hx: Pure Hypercholesterolemia
Systemic Meds: Crestor.
VA OD: Dcc20/20
VA OS: Dcc20/20
IOP: TP: OD:19 OS:10
|
|

Paracentral acute middle maculopathy - isolated96 views83 year old man New spot in the vision yesterday left eye.
Medical Hx: Pure Hypercholesterolemia
Systemic Meds: Crestor.
VA OD: Dcc20/20
VA OS: Dcc20/20
IOP: TP: OD:19 OS:10
|
|

Achromatopsia96 views28 year old female Good vision since birth started wearing glasses at 2, denies trauma. She does have congenital nystagmus.
VA OD: Dcc20/200-2 PH20/200 NccJ7
VA OS: Dcc20/160 PHNI NccJ7
IOP: TP: OD:15 OS:12
|
|

Macular edema from latanaprost96 views79 year old man with macula off RD repair 15 years ago and cataract surgery 14 years ago with new CME. Patient recently started on latanaprost VA 20/100 OD
|
|

Macular edema from latanaprost96 views79 year old man with macula off RD repair 15 years ago and cataract surgery 14 years ago with new CME. Patient recently started on latanaprost VA 20/100 OD
|
|

Posterior Pigment Dispersion Syndrome96 views81 year old man with cataract surgery 30 years ago and normal vision who had bilateral vitrectomy for dense floaters and has pigment on his IOL surface and all over the retina (but not on the cornea) VA 20/25 OU
|
|

Posterior Pigment Dispersion Syndrome96 views81 year old man with cataract surgery 30 years ago and normal vision who had bilateral vitrectomy for dense floaters and has pigment on his IOL surface and all over the retina (but not on the cornea) VA 20/25 OU
|
|

Retinal Arterial Macroaneurysm with pre-retinal hemorrhage96 views72 year old female who takes Xarelto had sudden vision loss while moving heavy furniture. VA was 20/200. The lesion has preretinal blood but later rebled with subretinal blood, was lasered and the final vision was not very good but the patient was lost to follow-up at 3 months
|
|

Retinal Arterial Macroaneurysm with pre-retinal hemorrhage96 views72 year old female who takes Xarelto had sudden vision loss while moving heavy furniture. VA was 20/200. The lesion has preretinal blood but later rebled with subretinal blood, was lasered and the final vision was not very good but the patient was lost to follow-up at 3 months
|
|

Fresh BRAO in patient with wet AMD96 views91 year old female She noticed last night a shadow over the left eye. When she closes her right eye she cannot see the bottom of the vision in the left eye. This is new.
VA OD: sc20/32-1
VA OS: sc20/32-2
|
|

PEHCR - Peripheral Exudative Hemorrhagic Chorioretinopathy96 views
|
|

PEHCR - Peripheral Exudative Hemorrhagic Chorioretinopathy96 views
|
|

Choroidal Melanocystosis96 views65 year old female with normal vision.
|
|

BRVO with good vision96 views87 year old man with good vision (diabetes without retinopathy). VA 20/25 OU. Vision never worsened from BRVO OS.
|
|

BRVO with good vision96 views87 year old man with good vision (diabetes without retinopathy). VA 20/25 OU. Vision never worsened from BRVO OS.
|
|

Normal RNFL scan96 views
|
|

Pseudophakic CME chronic96 views74 year old man presented 14 weeks after cataract surgery with severe CME on topical therapy. Multiple attempts to taper drops failed. Also, the patient had a steroid responsive glaucoma. He ended up on BID PF, Ketorolac and Dorz/Timolol
|
|

Myopic CNVM Left Eye96 views80 year old female. VA dropped to 20/125 but improved back up to 20/50 with Vabysmo
|
|

Myopic CNVM Left Eye96 views80 year old female. VA dropped to 20/125 but improved back up to 20/50 with Vabysmo
|
|

Choroidal Metastatic Breast Cancer with Exudative Detachment96 views58 year old female presented with 20/200 vision. Had 10 sessions of radiation and tumor shrank. The exudative detachment took almost a year to resolve. The vision improved to 20/40.
|
|

Hydroxychloroquine Toxicity96 views60 year old female received 6.5 mg/kg Plaquenil for 15 years and developed toxicity. VA 20/40 OD, 20/20 OS
|
|

NPDR and Severe macular ischemia sudden vision loss96 views60 year old female with sudden vision loss OD 1 week ago. VA 20/63, 20/200. OCT-A and FA shows severe macular ischemia OU
|
|

Laser pointer maculopathy95 views11 year old male When school started the patient noticed that he was having trouble reading and seeing out of both eyes. There are no retinal diseases in the family.
VA OD: sc20/25
VA OS: sc20/40
TP: OD:19 OS:18
The FOBSERD ZK-9318 laser pointer is a long range green beam high power flashlight. It has an average power of 60-90 mw.
You can buy the ZK-9318 laser pointer on Amazon
I also found this:
The FOBSERD ZK-9318 laser pointer is a class III laser with a 532nm wavelength and can be seen up to 1 mile away. It has a maximum power output of 5mW and creates a low-power visible laser beam.
One review on amazon says this:
Powerful
By Savvy Logic in the United States on March 17, 2023
I measured the wattage at about 150 MW on an optical Power Meter
|
|

Laser pointer maculopathy95 views11 year old male When school started the patient noticed that he was having trouble reading and seeing out of both eyes. There are no retinal diseases in the family.
VA OD: sc20/25
VA OS: sc20/40
TP: OD:19 OS:18
The FOBSERD ZK-9318 laser pointer is a long range green beam high power flashlight. It has an average power of 60-90 mw.
You can buy the ZK-9318 laser pointer on Amazon
I also found this:
The FOBSERD ZK-9318 laser pointer is a class III laser with a 532nm wavelength and can be seen up to 1 mile away. It has a maximum power output of 5mW and creates a low-power visible laser beam.
One review on amazon says this:
Powerful
By Savvy Logic in the United States on March 17, 2023
I measured the wattage at about 150 MW on an optical Power Meter
|
|

Laser pointer maculopathy95 views11 year old male When school started the patient noticed that he was having trouble reading and seeing out of both eyes. There are no retinal diseases in the family.
VA OD: sc20/25
VA OS: sc20/40
TP: OD:19 OS:18
The FOBSERD ZK-9318 laser pointer is a long range green beam high power flashlight. It has an average power of 60-90 mw.
You can buy the ZK-9318 laser pointer on Amazon
I also found this:
The FOBSERD ZK-9318 laser pointer is a class III laser with a 532nm wavelength and can be seen up to 1 mile away. It has a maximum power output of 5mW and creates a low-power visible laser beam.
One review on amazon says this:
Powerful
By Savvy Logic in the United States on March 17, 2023
I measured the wattage at about 150 MW on an optical Power Meter
|
|

Retinal Angioma95 views46 year old female - Her original reason for an eye examination was that she had been in a car accident. Then she saw that the vision was blurry in just the left eye. Prior to that she had no known vision changes. Since the accident she notices that her vision is better and her headaches are getting less bothersome.
PMhx benign, Meds: none
VA OD: Dcc20/20
VA OS: Dcc20/25
|
|

Paracentral acute middle maculopathy - isolated95 views83 year old man New spot in the vision yesterday left eye.
Medical Hx: Pure Hypercholesterolemia
Systemic Meds: Crestor.
VA OD: Dcc20/20
VA OS: Dcc20/20
IOP: TP: OD:19 OS:10
|
|

Paracentral acute middle maculopathy - isolated95 views83 year old man New spot in the vision yesterday left eye.
Medical Hx: Pure Hypercholesterolemia
Systemic Meds: Crestor.
VA OD: Dcc20/20
VA OS: Dcc20/20
IOP: TP: OD:19 OS:10
|
|

Paracentral acute middle maculopathy - isolated95 views83 year old man New spot in the vision yesterday left eye.
Medical Hx: Pure Hypercholesterolemia
Systemic Meds: Crestor.
VA OD: Dcc20/20
VA OS: Dcc20/20
IOP: TP: OD:19 OS:10
|
|

Paracentral acute middle maculopathy - isolated95 views83 year old man New spot in the vision yesterday left eye.
Medical Hx: Pure Hypercholesterolemia
Systemic Meds: Crestor.
VA OD: Dcc20/20
VA OS: Dcc20/20
IOP: TP: OD:19 OS:10
|
|

Achromatopsia95 views28 year old female Good vision since birth started wearing glasses at 2, denies trauma. She does have congenital nystagmus.
VA OD: Dcc20/200-2 PH20/200 NccJ7
VA OS: Dcc20/160 PHNI NccJ7
IOP: TP: OD:15 OS:12
|
|

Macular edema from latanaprost95 views79 year old man with macula off RD repair 15 years ago and cataract surgery 14 years ago with new CME. Patient recently started on latanaprost VA 20/100 OD
|
|

Posterior Pigment Dispersion Syndrome95 views81 year old man with cataract surgery 30 years ago and normal vision who had bilateral vitrectomy for dense floaters and has pigment on his IOL surface and all over the retina (but not on the cornea) VA 20/25 OU
|
|

Posterior Pigment Dispersion Syndrome95 views81 year old man with cataract surgery 30 years ago and normal vision who had bilateral vitrectomy for dense floaters and has pigment on his IOL surface and all over the retina (but not on the cornea) VA 20/25 OU
|
|

Posterior Pigment Dispersion Syndrome95 views81 year old man with cataract surgery 30 years ago and normal vision who had bilateral vitrectomy for dense floaters and has pigment on his IOL surface and all over the retina (but not on the cornea) VA 20/25 OU
|
|

Posterior Pigment Dispersion Syndrome95 views81 year old man with cataract surgery 30 years ago and normal vision who had bilateral vitrectomy for dense floaters and has pigment on his IOL surface and all over the retina (but not on the cornea) VA 20/25 OU
|
|

Retinal Arterial Macroaneurysm with pre-retinal hemorrhage95 views72 year old female who takes Xarelto had sudden vision loss while moving heavy furniture. VA was 20/200. The lesion has preretinal blood but later rebled with subretinal blood, was lasered and the final vision was not very good but the patient was lost to follow-up at 3 months
|
|

Choroidal Melanocystosis95 views65 year old female with normal vision.
|
|

BRVO with good vision95 views87 year old man with good vision (diabetes without retinopathy). VA 20/25 OU. Vision never worsened from BRVO OS.
|
|

Commotio - Bungee cord injury 2 days ago95 views
|
|

Myelinated Nerve Fiber Layer - Peripheral95 views43 year old man with floaters
|
|

Pattern Dystrophy - PHPR2 Gene95 views57 year old man- VA 20/25 OD, 20/20 OS - Many family members have retinitis pigmentosa
|
|

Choroidal Metastatic Breast Cancer with Exudative Detachment95 views58 year old female presented with 20/200 vision. Had 10 sessions of radiation and tumor shrank. The exudative detachment took almost a year to resolve. The vision improved to 20/40.
|
|

West Nile Virus Multifocal Choroiditis with later CNVM95 views77 year old female with vision loss in the left eye treated with Anti-VEGF
|
|

Idiopathic Polypoidal Choroidal Vasculopathy95 views83 year old man with wet AMD for 12 years resistant to Anti-VEGF therapy but responsive to PDT
|
|

Coats Plus Syndrome - Cerebroretinal microangiopathy with calcifications and cysts (CRMCC)95 views38 year old female CTC1 positive with Coats Plus Syndrome. This case was published https://pmc.ncbi.nlm.nih.gov/articles/PMC10649444/
|
|

Macular fold - resolved with time95 views
|
|

Phototoxicity following cataract surgery94 views70 year old female with nasal spot in vision since cataract surgery 3 years ago. VA 20/20 OU.
|
|

Laser pointer maculopathy94 views11 year old male When school started the patient noticed that he was having trouble reading and seeing out of both eyes. There are no retinal diseases in the family.
VA OD: sc20/25
VA OS: sc20/40
TP: OD:19 OS:18
The FOBSERD ZK-9318 laser pointer is a long range green beam high power flashlight. It has an average power of 60-90 mw.
You can buy the ZK-9318 laser pointer on Amazon
I also found this:
The FOBSERD ZK-9318 laser pointer is a class III laser with a 532nm wavelength and can be seen up to 1 mile away. It has a maximum power output of 5mW and creates a low-power visible laser beam.
One review on amazon says this:
Powerful
By Savvy Logic in the United States on March 17, 2023
I measured the wattage at about 150 MW on an optical Power Meter
|
|

Laser pointer maculopathy94 views11 year old male When school started the patient noticed that he was having trouble reading and seeing out of both eyes. There are no retinal diseases in the family.
VA OD: sc20/25
VA OS: sc20/40
TP: OD:19 OS:18
The FOBSERD ZK-9318 laser pointer is a long range green beam high power flashlight. It has an average power of 60-90 mw.
You can buy the ZK-9318 laser pointer on Amazon
I also found this:
The FOBSERD ZK-9318 laser pointer is a class III laser with a 532nm wavelength and can be seen up to 1 mile away. It has a maximum power output of 5mW and creates a low-power visible laser beam.
One review on amazon says this:
Powerful
By Savvy Logic in the United States on March 17, 2023
I measured the wattage at about 150 MW on an optical Power Meter
|
|

Paracentral acute middle maculopathy - isolated94 views83 year old man New spot in the vision yesterday left eye.
Medical Hx: Pure Hypercholesterolemia
Systemic Meds: Crestor.
VA OD: Dcc20/20
VA OS: Dcc20/20
IOP: TP: OD:19 OS:10
|
|

Paracentral acute middle maculopathy - isolated94 views83 year old man New spot in the vision yesterday left eye.
Medical Hx: Pure Hypercholesterolemia
Systemic Meds: Crestor.
VA OD: Dcc20/20
VA OS: Dcc20/20
IOP: TP: OD:19 OS:10
|
|

Achromatopsia94 views28 year old female Good vision since birth started wearing glasses at 2, denies trauma. She does have congenital nystagmus.
VA OD: Dcc20/200-2 PH20/200 NccJ7
VA OS: Dcc20/160 PHNI NccJ7
IOP: TP: OD:15 OS:12
|
|

Achromatopsia94 views28 year old female Good vision since birth started wearing glasses at 2, denies trauma. She does have congenital nystagmus.
VA OD: Dcc20/200-2 PH20/200 NccJ7
VA OS: Dcc20/160 PHNI NccJ7
IOP: TP: OD:15 OS:12
|
|

Macular edema from latanaprost94 views79 year old man with macula off RD repair 15 years ago and cataract surgery 14 years ago with new CME. Patient recently started on latanaprost VA 20/100 OD
|
|

Macular edema from latanaprost94 views79 year old man with macula off RD repair 15 years ago and cataract surgery 14 years ago with new CME. Patient recently started on latanaprost VA 20/100 OD
|
|

Posterior Pigment Dispersion Syndrome94 views81 year old man with cataract surgery 30 years ago and normal vision who had bilateral vitrectomy for dense floaters and has pigment on his IOL surface and all over the retina (but not on the cornea) VA 20/25 OU
|
|

Retinal Arterial Macroaneurysm with pre-retinal hemorrhage94 views72 year old female who takes Xarelto had sudden vision loss while moving heavy furniture. VA was 20/200. The lesion has preretinal blood but later rebled with subretinal blood, was lasered and the final vision was not very good but the patient was lost to follow-up at 3 months
|
|

Choroidal Melanocystosis94 views65 year old female with normal vision.
|
|

BRVO with good vision94 views87 year old man with good vision (diabetes without retinopathy). VA 20/25 OU. Vision never worsened from BRVO OS.
|
|

Pseudophakic CME chronic94 views74 year old man presented 14 weeks after cataract surgery with severe CME on topical therapy. Multiple attempts to taper drops failed. Also, the patient had a steroid responsive glaucoma. He ended up on BID PF, Ketorolac and Dorz/Timolol
|
|

Pseudophakic CME chronic94 views74 year old man presented 14 weeks after cataract surgery with severe CME on topical therapy. Multiple attempts to taper drops failed. Also, the patient had a steroid responsive glaucoma. He ended up on BID PF, Ketorolac and Dorz/Timolol
|
|

Pseudophakic CME chronic94 views74 year old man presented 14 weeks after cataract surgery with severe CME on topical therapy. Multiple attempts to taper drops failed. Also, the patient had a steroid responsive glaucoma. He ended up on BID PF, Ketorolac and Dorz/Timolol
|
|

Myopic CNVM Left Eye94 views80 year old female. VA dropped to 20/125 but improved back up to 20/50 with Vabysmo
|
|

Choroidal Metastatic Breast Cancer with Exudative Detachment94 views58 year old female presented with 20/200 vision. Had 10 sessions of radiation and tumor shrank. The exudative detachment took almost a year to resolve. The vision improved to 20/40.
|
|

Choroidal Metastatic Breast Cancer with Exudative Detachment94 views58 year old female presented with 20/200 vision. Had 10 sessions of radiation and tumor shrank. The exudative detachment took almost a year to resolve. The vision improved to 20/40.
|
|

West Nile Virus Multifocal Choroiditis with later CNVM94 views77 year old female with vision loss in the left eye treated with Anti-VEGF
|
|

Macular fold - resolved with time94 views
|
|

Serpiginous choroiditis in the right eye93 views68 year old female with spots in vision in the right eye for 2 months. She has a history of MS. The vision is 20/32 in both eyes. She was treated with high dose steroids and transitioned to methotrexate and the right eye quieted down.
|
|

Paracentral acute middle maculopathy - isolated93 views83 year old man New spot in the vision yesterday left eye.
Medical Hx: Pure Hypercholesterolemia
Systemic Meds: Crestor.
VA OD: Dcc20/20
VA OS: Dcc20/20
IOP: TP: OD:19 OS:10
|
|

Paracentral acute middle maculopathy - isolated93 views83 year old man New spot in the vision yesterday left eye.
Medical Hx: Pure Hypercholesterolemia
Systemic Meds: Crestor.
VA OD: Dcc20/20
VA OS: Dcc20/20
IOP: TP: OD:19 OS:10
|
|

Paracentral acute middle maculopathy - isolated93 views83 year old man New spot in the vision yesterday left eye.
Medical Hx: Pure Hypercholesterolemia
Systemic Meds: Crestor.
VA OD: Dcc20/20
VA OS: Dcc20/20
IOP: TP: OD:19 OS:10
|
|

Paracentral acute middle maculopathy - isolated93 views83 year old man New spot in the vision yesterday left eye.
Medical Hx: Pure Hypercholesterolemia
Systemic Meds: Crestor.
VA OD: Dcc20/20
VA OS: Dcc20/20
IOP: TP: OD:19 OS:10
|
|

Paracentral acute middle maculopathy - isolated93 views83 year old man New spot in the vision yesterday left eye.
Medical Hx: Pure Hypercholesterolemia
Systemic Meds: Crestor.
VA OD: Dcc20/20
VA OS: Dcc20/20
IOP: TP: OD:19 OS:10
|
|

Achromatopsia93 views28 year old female Good vision since birth started wearing glasses at 2, denies trauma. She does have congenital nystagmus.
VA OD: Dcc20/200-2 PH20/200 NccJ7
VA OS: Dcc20/160 PHNI NccJ7
IOP: TP: OD:15 OS:12
|
|

Posterior Pigment Dispersion Syndrome93 views81 year old man with cataract surgery 30 years ago and normal vision who had bilateral vitrectomy for dense floaters and has pigment on his IOL surface and all over the retina (but not on the cornea) VA 20/25 OU
|
|

Retinal Arterial Macroaneurysm with pre-retinal hemorrhage93 views72 year old female who takes Xarelto had sudden vision loss while moving heavy furniture. VA was 20/200. The lesion has preretinal blood but later rebled with subretinal blood, was lasered and the final vision was not very good but the patient was lost to follow-up at 3 months
|
|

Retinal Arterial Macroaneurysm with pre-retinal hemorrhage93 views72 year old female who takes Xarelto had sudden vision loss while moving heavy furniture. VA was 20/200. The lesion has preretinal blood but later rebled with subretinal blood, was lasered and the final vision was not very good but the patient was lost to follow-up at 3 months
|
|

wet AMD with classic extrafoveal macular neovascularization in the good eye93 views89 year old man with longstanding vision loss in the left eye presented with one month of mild vision loss in the right eye. Vision was 20/32. This eye responded to vabysmo therapy.
|
|

wet AMD with classic extrafoveal macular neovascularization in the good eye93 views89 year old man with longstanding vision loss in the left eye presented with one month of mild vision loss in the right eye. Vision was 20/32. This eye responded to vabysmo therapy.
|
|
| 17965 files on 180 page(s) |
 |
 |
 |
 |
 |
170 |  |
 |
 |
 |
|